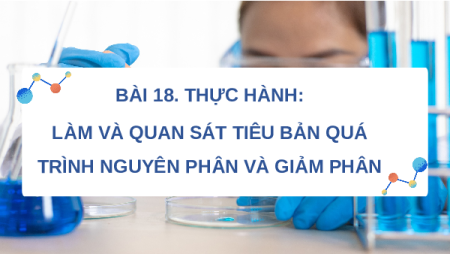

VUI MỪNG CHÀO ĐÓN CÁC EM ĐẾN VỚI BÀI HỌC HÔM NAY! KHỞI ĐỘNG
Trình bày ngắn gọn quá trình nguyên phân, giảm phân và nêu
điểm giống nhau, khác nhau cơ bản giữa hai quá trình này.
BÀI 18. THỰC HÀNH:
LÀM VÀ QUAN SÁT TIÊU BẢN QUÁ
TRÌNH NGUYÊN PHÂN VÀ GIẢM PHÂN NỘI DUNG BÀI HỌC 1. Chuẩn bị 2. Cách tiến hành 3. Thu hoạch
Giáo án Powerpoint Thực hành làm và quan sát tiêu bản quá trình nguyên phân và giảm phân Sinh học 10 Kết nối tri thức
660
330 lượt tải
MUA NGAY ĐỂ XEM TOÀN BỘ TÀI LIỆU
CÁCH MUA:
- B1: Gửi phí vào TK:
1133836868- CT TNHH DAU TU VA DV GD VIETJACK - Ngân hàng MB (QR) - B2: Nhắn tin tới Zalo VietJack Official ( nhấn vào đây ) để xác nhận thanh toán và tải tài liệu - giáo án
Liên hệ ngay Hotline hỗ trợ: 084 283 45 85
Bộ bài giảng điện tử Sinh học 10 Kết nối tri thức được cập nhật liên tục trong gói này từ nay đến hết tháng 3/2024.
Để tải tài liệu gốc về máy bạn click vào nút Tải Xuống ở trên!
Thuộc bộ (mua theo bộ để tiết kiệm hơn):
- Bộ bài giảng powerpoint Sinh học 10 Kết nối tri thức bao gồm đầy đủ các bài giảng cả năm. Bộ bài giảng được thiết kế theo phong cách hiện đại, đẹp mắt, trình bày chi tiết cho từng phần học và bám sát chương trình Sách giáo khoa Sinh học 10 Kết nối tri thức.
- Mua trọn bộ sẽ tiết kiệm hơn tải lẻ 50%.
Đánh giá
4.6 / 5(660 )5
4
3
2
1
Trọng Bình
Tài liệu hay
Giúp ích cho tôi rất nhiều
Duy Trần
Tài liệu chuẩn
Rất thích tài liệu bên VJ soạn (bám sát chương trình dạy)
TÀI LIỆU BỘ BÁN CHẠY MÔN Sinh Học
Xem thêmTÀI LIỆU BỘ BÁN CHẠY Lớp 10
Xem thêmTài liệu bộ mới nhất

VUI MỪNG CHÀO ĐÓN CÁC
EM ĐẾN VỚI
BÀI HỌC HÔM NAY!

Trình bày ngắn gọn quá trình nguyên phân, giảm phân và nêu
điểm giống nhau, khác nhau cơ bản giữa hai quá trình này.
KHỞI ĐỘNG

"BÀI 18. THỰC HÀNH:
LÀM VÀ QUAN SÁT TIÊU BẢN QUÁ
TRÌNH NGUYÊN PHÂN VÀ GIẢM PHÂN

NỘI DUNG BÀI HỌC
1. Chuẩn bị
2. Cách tiến hành
3. Thu hoạch

I. CHUẨN BỊ
1. Dụng cụ: kính hiển vi quang học, lam kính,
lamen, đĩa đồng hồ, giấy thấm, kéo, kim mũi
mác, ống nhỏ giọt, bếp cồn hoặc bếp điện.
2. Hóa chất: nước cất; dung dịch cố định các
kì của nguyên phân; thuốc nhuộm
acetocarmine 2%.